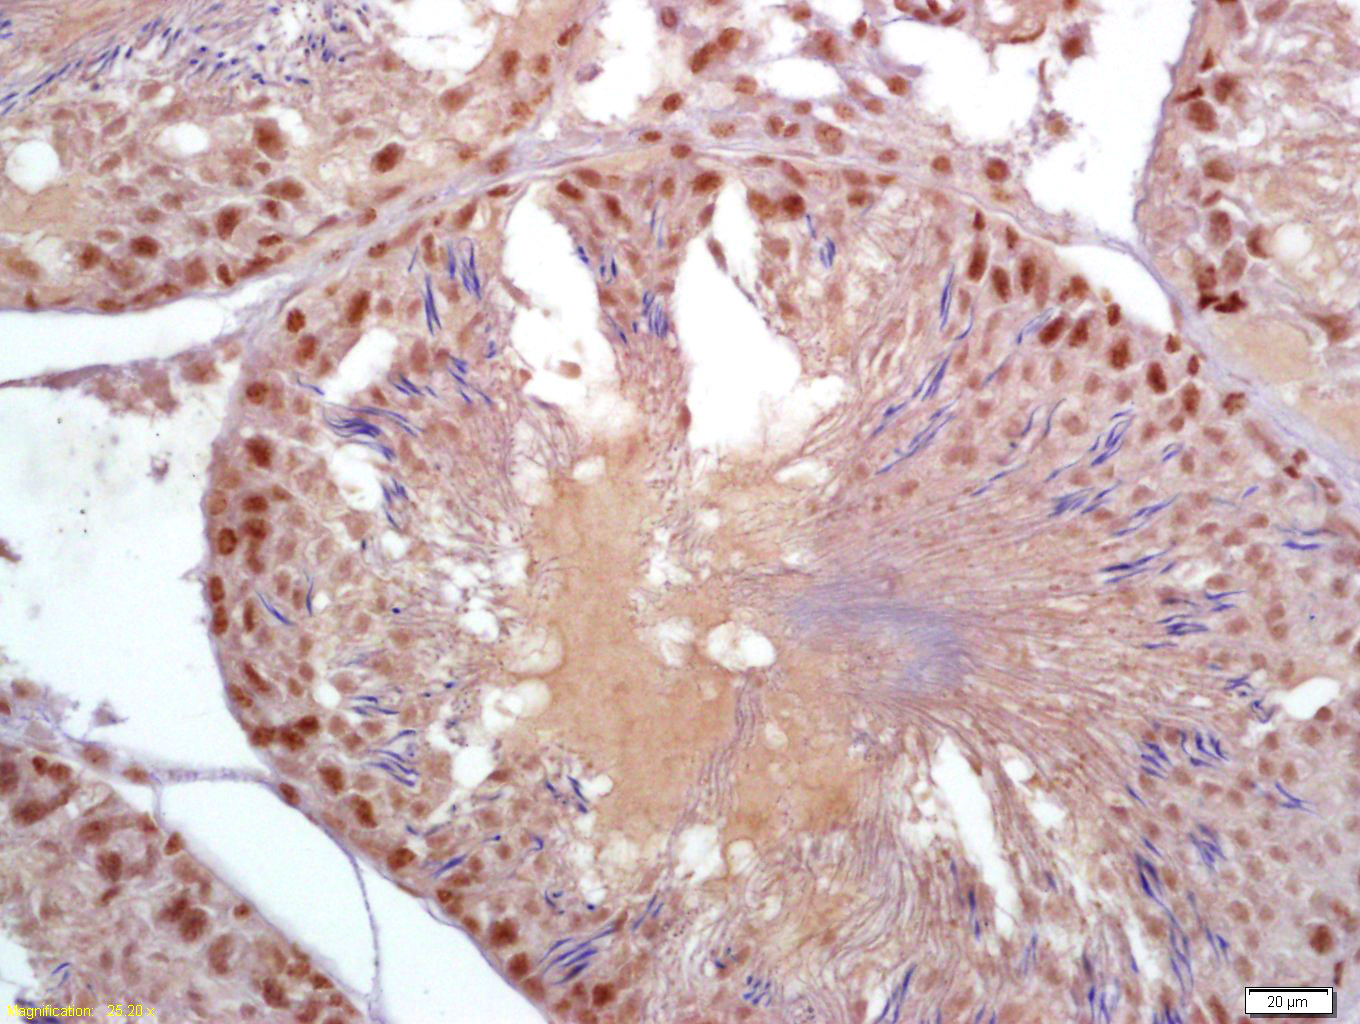
帕金蛋白抗体-bs-1865R

Cell Biology > Proteolysis / Ubiquitin > Proteasome / Ubiquitin > Ubiquitin E3 Enzymes > RING Finger E3 Ligase
Metabolism > Pathways and Processes > Mitochondrial Metabolism > Mitophagy fission and fusion
Neuroscience > Neurology process > Neurodegenerative disease > Parkinson's disease > Parkin / PARK

| 应用 | 已检合格种属 | 预测种属 | 推荐稀释比例 |
|---|---|---|---|
| IHC-P | Rat | Human, Mouse, Pig | 1:100-500 |
| IHC-F | Rat | Human, Mouse, Pig | 1:100-500 |
| IF | Rat | Human, Mouse, Pig | 1:100-500 |
交叉反应: Rat (predicted: Human, Mouse, Pig)
暂无相关产品